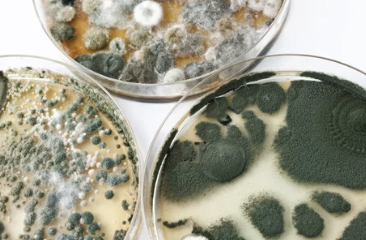

๊ณฐํก์ด ์ ๊ฑฐ๋ฐฉ๋ฒ TOP5 ์์๋ณด๊ธฐ โ
- ์นดํ ๊ณ ๋ฆฌ ์์
- 2024. 6. 26. 21:48
๐ฆ ๊ณฐํก์ด, ์ด์ ์๋ ! ๐ 2024๋ ์ต์ ๊ณฐํก์ด ์ ๊ฑฐ ๋ฐฉ๋ฒ TOP 5 ์๋ฒฝ ์ ๋ณต (ft. ๊ณฐํก์ด ๋ฐฉ์ง ๊ฟํ ๋๋ฐฉ์ถ!)
๐ญ ํน์ ์ง์ ๊ณณ๊ณณ์ ๊ณฐํก์ด๊ฐ ์ค๋ฉ์ค๋ฉ ํผ์ด๋๊ณ ์๋์?
ํดํดํ ๋์์ ํจ๊ป ๊ฑด๊ฐ๊น์ง ์ํํ๋ ๊ณฐํก์ด! ํนํ ์ตํ ์ฌ๋ฆ์ฒ ์ด๋ ํ์ ๊ธฐ์๋ ๋์ฑ ๊ธฐ์น์ ๋ถ๋ฆฌ์ฃ . ๊ณฐํก์ด๋ ๋ฏธ๊ด์ ์ข์ง ์์ ๋ฟ๋ง ์๋๋ผ ์๋ ๋ฅด๊ธฐ, ํธํก๊ธฐ ์งํ, ํผ๋ถ ์งํ ๋ฑ ๋ค์ํ ๊ฑด๊ฐ ๋ฌธ์ ๋ฅผ ์ผ์ผํฌ ์ ์์ต๋๋ค.
ํ์ง๋ง ๊ฑฑ์ ๋ง์ธ์! ๊ณฐํก์ด๋ ์ฌ๋ฐ๋ฅธ ๋ฐฉ๋ฒ์ผ๋ก ์ ๊ฑฐํ๊ณ ์๋ฐฉํ๋ฉด ์ถฉ๋ถํ ํด์นํ ์ ์์ต๋๋ค. ์ค๋์ 2024๋ ์ต์ ์ ๋ณด๋ฅผ ๋ฐํ์ผ๋ก ๊ณฐํก์ด ์ ๊ฑฐ ๋ฐฉ๋ฒ TOP 5๋ฅผ ๋ฑ๋ฑ์ด ํํค์ณ ๋๋ฆฝ๋๋ค. ๊ณฐํก์ด ์ข ๋ฅ๋ณ ๋ง์ถค ์ ๊ฑฐ๋ฒ๋ถํฐ ๊ณฐํก์ด ๋ฐฉ์ง ๊ฟํ๊น์ง! ์ด ๊ธ์ ํตํด ๊ณฐํก์ด ์๋ ๊นจ๋ํ๊ณ ๊ฑด๊ฐํ ์ง์ ๋ง๋ค์ด๋ณด์ธ์!
1๏ธโฃ ๊ณฐํก์ด, ์ ์๊ธฐ๋ ๊ฑธ๊น์? (๊ณฐํก์ด ๋ฐ์ ์์ธ๊ณผ ์ข ๋ฅ ์ฌ์ธต ๋ถ์)

๊ณฐํก์ด๋ ์ตํ๊ณ ๋ฐ๋ปํ ํ๊ฒฝ์ ์ข์ํ๋ ๊ท ๋ฅ์ ๋๋ค. ์ต๋๊ฐ ๋๊ณ ํ๊ธฐ๊ฐ ์ ์ ๋๋ ๊ณณ, ํ๋น์ด ์ ๋ค์ง ์๋ ๊ณณ, ๊ฒฐ๋ก๊ฐ ๋ฐ์ํ๋ ๊ณณ ๋ฑ์์ ์ฝ๊ฒ ๋ฒ์ํ์ฃ .
๊ณฐํก์ด๋ ์ข ๋ฅ์ ๋ฐ๋ผ ์๊น, ํํ, ๋ฐ์ ์์น ๋ฑ์ด ๋ค๋ฆ ๋๋ค.
- ๊ฒ์ ๊ณฐํก์ด: ์์ค, ์ฃผ๋ฐฉ, ๋ฒ ๋๋ค ๋ฑ ์ต๊ธฐ๊ฐ ๋ง์ ๊ณณ์์ ์์ฃผ ๋ฐ๊ฒฌ๋ฉ๋๋ค. ์๋ ๋ฅด๊ธฐ, ํธํก๊ธฐ ์งํ์ ์ ๋ฐํ ์ ์์ต๋๋ค.
- ํธ๋ฅธ ๊ณฐํก์ด: ๋นต, ๊ณผ์ผ, ์ฑ์ ๋ฑ ์์๋ฌผ์ ์ฃผ๋ก ๋ฐ์ํฉ๋๋ค. ์์ค๋ ์ ์ผ์ผํฌ ์ ์์ต๋๋ค.
- ๋ถ์ ๊ณฐํก์ด: ์์ค ํ์ผ, ๋ฒฝ์ง ๋ฑ์ ์ฃผ๋ก ๋ฐ์ํฉ๋๋ค. ๋ฏธ๊ด์ ์ข์ง ์์ ๋ฟ๋ง ์๋๋ผ ๊ฑด๊ฐ์๋ ์ข์ง ์์ต๋๋ค.
- ํฐ์ ๊ณฐํก์ด: ์ท, ๊ฐ์ฃฝ ์ ํ, ๋๋ฌด ๋ฑ ๋ค์ํ ๊ณณ์์ ๋ฐ์ํฉ๋๋ค. ์ฌ์ ๋ฅผ ์์์ํค๊ณ ์ ์ทจ๋ฅผ ์ ๋ฐํฉ๋๋ค.
2๏ธโฃ ๊ณฐํก์ด, ์ด๋ป๊ฒ ์ ๊ฑฐํ ๊น์? (ํจ๊ณผ์ ์ธ ๊ณฐํก์ด ์ ๊ฑฐ ๋ฐฉ๋ฒ TOP 5)



๊ณฐํก์ด ์ ๊ฑฐ ๋ฐฉ๋ฒ์ ๊ณฐํก์ด ์ข ๋ฅ, ๋ฐ์ ์์น, ์ฌ๊ฐ๋์ ๋ฐ๋ผ ๋ฌ๋ผ์ง๋๋ค. ํ์ง๋ง ๋ค์ 5๊ฐ์ง ๋ฐฉ๋ฒ์ ๋๋ถ๋ถ์ ๊ณฐํก์ด ์ ๊ฑฐ์ ํจ๊ณผ์ ์ ๋๋ค.
- ๋ฒ ์ดํน ์๋ค + ์์ด: ๋ฒ ์ดํน ์๋ค์ ์์ด๋ฅผ 1:1 ๋น์จ๋ก ์์ด ๊ณฐํก์ด๊ฐ ์๊ธด ๊ณณ์ ๋ฟ๋ฆฌ๊ณ ์๋ก ๋ฌธ์ง๋ฆ ๋๋ค. 30๋ถ ํ ๋ฌผ๋ก ๊นจ๋ํ๊ฒ ๋ฆ์๋ด๋ฉด ๊ณฐํก์ด ์ ๊ฑฐ์ ์ด๊ท ํจ๊ณผ๋ฅผ ๋์์ ์ป์ ์ ์์ต๋๋ค.
- ๊ณผํ์ฐ์๋ค: ๊ณผํ์ฐ์๋ค๋ ํ๋ฐฑ, ์ด๊ท ํจ๊ณผ๊ฐ ๋ฐ์ด๋ ํฐ ๊ณฐํก์ด ์ ๊ฑฐ์ ํนํ ํจ๊ณผ์ ์ ๋๋ค. ๋ฐ๋ปํ ๋ฌผ์ ๊ณผํ์ฐ์๋ค๋ฅผ ๋ น์ฌ ๊ณฐํก์ด๊ฐ ์๊ธด ๊ณณ์ ๋ฟ๋ฆฌ๊ณ 30๋ถ ํ ๋ฆ์๋ด๋ฉด ๋ฉ๋๋ค.
- ๋ฝ์ค: ๋ฝ์ค๋ ๊ฐ๋ ฅํ ์ด๊ท ํจ๊ณผ๊ฐ ์์ด ์์ค ํ์ผ, ๋ณ๊ธฐ ๋ฑ ๊ณฐํก์ด ์ ๊ฑฐ์ ํจ๊ณผ์ ์ ๋๋ค. ํ์ง๋ง ๋ฝ์ค๋ ๋ ์ฑ์ด ๊ฐํ๋ฏ๋ก ํ๊ธฐ๊ฐ ์ ๋๋ ๊ณณ์์ ์ฌ์ฉํด์ผ ํ๋ฉฐ, ํผ๋ถ์ ๋ฟ์ง ์๋๋ก ์ฃผ์ํด์ผ ํฉ๋๋ค.
- ๊ณฐํก์ด ์ ๊ฑฐ์ : ์์ค์ ํ๋งค๋๋ ๊ณฐํก์ด ์ ๊ฑฐ์ ๋ ๊ฐํธํ๊ฒ ๊ณฐํก์ด๋ฅผ ์ ๊ฑฐํ ์ ์๋ ๋ฐฉ๋ฒ์ ๋๋ค. ํ์ง๋ง ๊ณฐํก์ด ์ ๊ฑฐ์ ๋ ํํ ์ฑ๋ถ์ด๋ฏ๋ก ์ฌ์ฉ ์ ํ๊ธฐ๋ฅผ ์ ํด์ผ ํ๋ฉฐ, ํผ๋ถ์ ๋ฟ์ง ์๋๋ก ์ฅ๊ฐ์ ์ฐฉ์ฉํด์ผ ํฉ๋๋ค.
- ์ ๋ฌธ ์ ์ฒด: ๊ณฐํก์ด๊ฐ ์ฌํ๊ฒ ๋ฒ์ํ๊ฑฐ๋ ๋์ ๋ฉด์ ์ ๋ฐ์ํ ๊ฒฝ์ฐ์๋ ์ ๋ฌธ ์ ์ฒด์ ์๋ขฐํ๋ ๊ฒ์ด ์ข์ต๋๋ค. ์ ๋ฌธ ์ ์ฒด๋ ๊ณฐํก์ด ์ ๊ฑฐ ์ ๋ฌธ ์ฅ๋น์ ์ฝํ์ ์ฌ์ฉํ์ฌ ๊ณฐํก์ด๋ฅผ ์๋ฒฝํ๊ฒ ์ ๊ฑฐํ๊ณ ์ฌ๋ฐ์ ๋ฐฉ์งํฉ๋๋ค.
3๏ธโฃ ๊ณฐํก์ด, ์ด๋์ ์ ์๊ธธ๊น์? (๊ณฐํก์ด ๋ฐ์ ์ทจ์ฝ ์ฅ์๋ณ ์ ๊ฑฐ ๋ฐฉ๋ฒ)



๊ณฐํก์ด๋ ์ต๊ธฐ๊ฐ ๋ง์ ๊ณณ์ ์ ์๊ธฐ๋ฏ๋ก, ์์ค, ์ฃผ๋ฐฉ, ๋ฒ ๋๋ค, ๋ฒฝ์ง, ์ฅํ ๋ฑ ์ต๊ธฐ๊ฐ ์ฐจ๊ธฐ ์ฌ์ด ๊ณณ์ ์ค์ฌ์ผ๋ก ๊ผผ๊ผผํ๊ฒ ๊ด๋ฆฌํด์ผ ํฉ๋๋ค.
- ์์ค: ์์ค์ ์ต๋๊ฐ ๋๊ณ ํ๊ธฐ๊ฐ ์ ์ ๋๋ ๊ณณ์ด๋ฏ๋ก ๊ณฐํก์ด๊ฐ ๋ฒ์ํ๊ธฐ ์ฝ์ต๋๋ค. ์ค์ ํ์๋ ํํ๊ธฐ๋ฅผ ์ผ๊ณ , ์ฐฝ๋ฌธ์ ์ด์ด ํ๊ธฐ๋ฅผ ์์ผ์ผ ํฉ๋๋ค. ํ์ผ ์ฌ์ด๋ ์ค๋ฆฌ์ฝ ๋ถ๋ถ์ ๊ณฐํก์ด๊ฐ ์๊ฒผ๋ค๋ฉด ๋ฝ์ค๋ ๊ณฐํก์ด ์ ๊ฑฐ์ ๋ฅผ ์ฌ์ฉํ์ฌ ์ ๊ฑฐํ๊ณ , ๊ณฐํก์ด ๋ฐฉ์ง ํ ์ดํ๋ฅผ ๋ถ์ฌ ์ฌ๋ฐ์ ๋ฐฉ์งํ ์ ์์ต๋๋ค.
- ์ฃผ๋ฐฉ: ์ฃผ๋ฐฉ์ ์์๋ฌผ ์ฐ๊บผ๊ธฐ๋ ๊ธฐ๋ฆ๋๋ก ์ธํด ๊ณฐํก์ด๊ฐ ์๊ธฐ๊ธฐ ์ฝ์ต๋๋ค. ์กฐ๋ฆฌ ํ์๋ ๋ฐ๋ก ์ฒญ์ํ๊ณ , ์ฑํฌ๋ ๋ฐฐ์๊ตฌ๋ ์ ๊ธฐ์ ์ผ๋ก ์ฒญ์ํด์ผ ํฉ๋๋ค. ๋์ฅ๊ณ ๊ณ ๋ฌด ํจํน์๋ ๊ณฐํก์ด๊ฐ ์๊ธธ ์ ์์ผ๋ฏ๋ก, ์ ์ ํ์ฃผ๋ก ๋ฆ์์ฃผ๊ณ ๋ง๋ฅธ ํ์ฃผ๋ก ๋ฌผ๊ธฐ๋ฅผ ์ ๊ฑฐํด์ผ ํฉ๋๋ค.
- ๋ฒ ๋๋ค: ๋ฒ ๋๋ค๋ ์ธ๋ถ์ ์ ์ดํ๋ ๊ณต๊ฐ์ผ๋ก ์ต๋ ๋ณํ๊ฐ ํฌ๊ณ ๊ฒฐ๋ก๊ฐ ๋ฐ์ํ๊ธฐ ์ฌ์ ๊ณฐํก์ด๊ฐ ์๊ธฐ๊ธฐ ์ฝ์ต๋๋ค. ๋ฒ ๋๋ค ์ฐฝ๋ฌธ์ ์์ฃผ ์ด์ด ํ๊ธฐ๋ฅผ ์ํค๊ณ , ์ต๋ ์กฐ์ ์ ์ํด ์ ์ต๊ธฐ๋ฅผ ์ฌ์ฉํ๋ ๊ฒ๋ ์ข์ต๋๋ค.
- ๋ฒฝ์ง, ์ฅํ: ๋ฒฝ์ง๋ ์ฅํ์ ๊ณฐํก์ด๊ฐ ์๊ฒผ๋ค๋ฉด ๊ณฐํก์ด ์ ๊ฑฐ์ ๋ฅผ ์ฌ์ฉํ์ฌ ์ ๊ฑฐํ๊ณ , ๊ณฐํก์ด ๋ฐฉ์ง ํ์ธํธ๋ฅผ ์น ํ๋ ๊ฒ์ด ์ข์ต๋๋ค.
- ์ท์ฅ, ์ ๋ฐ์ฅ: ์ท์ฅ์ด๋ ์ ๋ฐ์ฅ์ ์ต๊ธฐ๊ฐ ์ฐจ๊ธฐ ์ฌ์ ๊ณฐํก์ด๊ฐ ์๊ธธ ์ ์์ต๋๋ค. ์ท์ด๋ ์ ๋ฐ์ ๋ณด๊ดํ๊ธฐ ์ ์ ์์ ํ ๊ฑด์กฐํ๊ณ , ์ต๊ธฐ ์ ๊ฑฐ์ ๋ฅผ ์ฌ์ฉํ๋ ๊ฒ์ด ์ข์ต๋๋ค.
4๏ธโฃ ๊ณฐํก์ด, ๋ค์๋ ๋ณด๊ณ ์ถ์ง ์์์! (๊ณฐํก์ด ๋ฐฉ์ง ๊ฟํ ๋๋ฐฉ์ถ)



๊ณฐํก์ด๋ฅผ ์๋ฐฉํ๋ ค๋ฉด ๋ค์๊ณผ ๊ฐ์ ๊ฟํ๋ค์ ์ค์ฒํด ๋ณด์ธ์.
- ํ๊ธฐ: ํ๋ฃจ 3๋ฒ, 30๋ถ ์ด์ ์ฐฝ๋ฌธ์ ์ด์ด ํ๊ธฐ๋ฅผ ์ํค๋ ๊ฒ์ด ์ข์ต๋๋ค. ํนํ ์ต๋๊ฐ ๋์ ์ฌ๋ฆ์ฒ ์ด๋ ๋น๊ฐ ์ค๋ ๋ ์๋ ๋์ฑ ์์ฃผ ํ๊ธฐ๋ฅผ ์์ผ์ผ ํฉ๋๋ค.
- ์ ์ต: ์ต๋๊ฐ ๋์ ๊ณณ์๋ ์ ์ต๊ธฐ๋ฅผ ์ฌ์ฉํ๊ฑฐ๋ ์ฏ, ๊ตต์ ์๊ธ ๋ฑ ์ฒ์ฐ ์ ์ต์ ๋ฅผ ํ์ฉํ์ฌ ์ต๋๋ฅผ ๋ฎ์ถฐ์ผ ํฉ๋๋ค.
- ๋จ์ด: ๊ฒฐ๋ก๊ฐ ๋ฐ์ํ๋ ๊ณณ์๋ ๋จ์ด์ฌ๋ฅผ ์ค์นํ๊ฑฐ๋ ๋จ์ด ํ์ธํธ๋ฅผ ์น ํ์ฌ ๊ณฐํก์ด ๋ฐ์์ ์๋ฐฉํ ์ ์์ต๋๋ค.
- ์ฒญ์: ๋จผ์ง๋ ์์๋ฌผ ์ฐ๊บผ๊ธฐ ๋ฑ ๊ณฐํก์ด๊ฐ ๋ฒ์ํ๊ธฐ ์ข์ ํ๊ฒฝ์ ์ ๊ฑฐํ๊ธฐ ์ํด ์ฃผ๊ธฐ์ ์ผ๋ก ์ฒญ์ํด์ผ ํฉ๋๋ค.
- ํ๋น: ํ๋น์ ๊ณฐํก์ด ๋ฒ์์ ์ต์ ํ๋ ํจ๊ณผ๊ฐ ์์ต๋๋ค. ํ๋น์ด ์ ๋๋ ๊ณณ์ ์ท์ด๋ ์ด๋ถ์ ๋ง๋ฆฌ๊ณ , ์ท์ฅ์ด๋ ์ ๋ฐ์ฅ ๋ฌธ์ ์ด์ด ํ๋น์ ์ฌ์ด์ฃผ๋ ๊ฒ์ด ์ข์ต๋๋ค.
5๏ธโฃ ๊ณฐํก์ด ์ ๊ฑฐ, ์ ๋ฌธ๊ฐ์๊ฒ ๋งก๊ฒจ์ผ ํ ๊น์? (์ ํ ์ ๊ฑฐ vs ์ ๋ฌธ ์ ์ฒด ๋น๊ต)



๊ณฐํก์ด ์ ๊ฑฐ๋ ์ ํ๋ก๋ ๊ฐ๋ฅํ์ง๋ง, ๊ณฐํก์ด ์ข ๋ฅ, ๋ฐ์ ๋ฒ์, ์ฌ๊ฐ๋์ ๋ฐ๋ผ ์ ๋ฌธ ์ ์ฒด์ ์๋ขฐํ๋ ๊ฒ์ด ๋ ํจ๊ณผ์ ์ผ ์ ์์ต๋๋ค.
- ์ ํ ์ ๊ฑฐ: ๊ณฐํก์ด ๋ฐ์ ๋ฒ์๊ฐ ์ข๊ณ ์ฌ๊ฐํ์ง ์์ ๊ฒฝ์ฐ์๋ ์ ํ ์ ๊ฑฐ๊ฐ ๊ฐ๋ฅํฉ๋๋ค. ํ์ง๋ง ๊ณฐํก์ด ์ ๊ฑฐ์ ์ฌ์ฉ ์ํ๊ธฐ์ ์์ ์ ์ ์ํด์ผ ํฉ๋๋ค.
- ์ ๋ฌธ ์ ์ฒด: ๊ณฐํก์ด ๋ฐ์ ๋ฒ์๊ฐ ๋๊ฑฐ๋ ์ฌ๊ฐํ ๊ฒฝ์ฐ, ๋๋ ๊ณฐํก์ด ์ข ๋ฅ๋ฅผ ์ ํํ ์ ์ ์๋ ๊ฒฝ์ฐ์๋ ์ ๋ฌธ ์ ์ฒด์ ์๋ขฐํ๋ ๊ฒ์ด ์ข์ต๋๋ค. ์ ๋ฌธ ์ ์ฒด๋ ๊ณฐํก์ด ์ ๊ฑฐ ์ ๋ฌธ ์ฅ๋น์ ์ฝํ์ ์ฌ์ฉํ์ฌ ๊ณฐํก์ด๋ฅผ ์๋ฒฝํ๊ฒ ์ ๊ฑฐํ๊ณ ์ฌ๋ฐ ๋ฐฉ์ง ์๊ณต๊น์ง ํด์ค๋๋ค.
6๏ธโฃ ๊ณฐํก์ด, ์ฐ๋ฆฌ ์ง์์ ์์ํ ์ถ๋ฐฉ! (๊ณฐํก์ด ์ ๊ฑฐ ํ ๊ด๋ฆฌ ๋ฐ ์๋ฐฉ๋ฒ)






๊ณฐํก์ด๋ฅผ ์ ๊ฑฐํ ํ์๋ ๊พธ์คํ ๊ด๋ฆฌ์ ์๋ฐฉ์ด ํ์ํฉ๋๋ค. ๊ณฐํก์ด๊ฐ ๋ค์ ์๊ธฐ์ง ์๋๋ก ๋ค์ ์ฌํญ์ ๊ผญ ์ง์ผ์ฃผ์ธ์.
- ํ๊ธฐ ์ต๊ดํ: ํ๋ฃจ 3๋ฒ, 30๋ถ ์ด์ ์ฐฝ๋ฌธ์ ์ด์ด ํ๊ธฐ๋ฅผ ์์ผ์ฃผ์ธ์. ํนํ ์ต๋๊ฐ ๋์ ์ฌ๋ฆ์ฒ ์ด๋ ๋น ์ค๋ ๋ ์๋ ๋์ฑ ์ ๊ฒฝ ์จ์ผ ํฉ๋๋ค.
- ์ ์ต๊ธฐ ํ์ฉ: ์ต๋๊ฐ ๋์ ๊ณณ์๋ ์ ์ต๊ธฐ๋ฅผ ์ฌ์ฉํ์ฌ ์ต๋๋ฅผ 50% ์ดํ๋ก ์ ์งํ๋ ๊ฒ์ด ์ข์ต๋๋ค.
- ๊ฒฐ๋ก ๋ฐฉ์ง: ๊ฒฐ๋ก๊ฐ ๋ฐ์ํ๋ ๊ณณ์๋ ๋จ์ด์ฌ๋ฅผ ๋ณด๊ฐํ๊ฑฐ๋ ๋จ์ด ํ์ธํธ๋ฅผ ์น ํ์ฌ ๊ณฐํก์ด ๋ฐ์์ ์๋ฐฉํ ์ ์์ต๋๋ค.
- ์ฃผ๊ธฐ์ ์ธ ์ฒญ์: ๋จผ์ง๋ ์์๋ฌผ ์ฐ๊บผ๊ธฐ ๋ฑ ๊ณฐํก์ด๊ฐ ๋ฒ์ํ๊ธฐ ์ข์ ํ๊ฒฝ์ ์ ๊ฑฐํ๊ธฐ ์ํด ์ฃผ๊ธฐ์ ์ผ๋ก ์ฒญ์ํด์ผ ํฉ๋๋ค. ํนํ ์์ค, ์ฃผ๋ฐฉ, ๋ฒ ๋๋ค ๋ฑ ์ต๊ธฐ๊ฐ ๋ง์ ๊ณณ์ ๋์ฑ ์ ๊ฒฝ ์จ์ ์ฒญ์ํด์ผ ํฉ๋๋ค.
- ๊ณฐํก์ด ๋ฐฉ์ง ์ฝํ : ๊ณฐํก์ด๊ฐ ์์ฃผ ๋ฐ์ํ๋ ๊ณณ์๋ ๊ณฐํก์ด ๋ฐฉ์ง ์ฝํ ์ ๋ฅผ ์ฌ์ฉํ์ฌ ๊ณฐํก์ด ์ฌ๋ฐ์ ๋ง์ ์ ์์ต๋๋ค.
- ์๋ฌผ ๊ด๋ฆฌ: ์ค๋ด์์ ์๋ฌผ์ ํค์ฐ๋ ๊ฒฝ์ฐ, ํ๋ถ ๋ฐ์นจ๋์ ๋ฌผ์ด ๊ณ ์ด์ง ์๋๋ก ์ฃผ์ํ๊ณ , ์์ ๋ฌผ์ด ๋ฟ์ง ์๋๋ก ํด์ผ ํฉ๋๋ค.
- ์ท์ฅ, ์ ๋ฐ์ฅ ๊ด๋ฆฌ: ์ท์ด๋ ์ ๋ฐ์ ๋ณด๊ดํ๊ธฐ ์ ์ ์์ ํ ๊ฑด์กฐํ๊ณ , ์ต๊ธฐ ์ ๊ฑฐ์ ๋ฅผ ์ฌ์ฉํ๋ ๊ฒ์ด ์ข์ต๋๋ค. ์ท์ฅ์ด๋ ์ ๋ฐ์ฅ ๋ฌธ์ ์ฃผ๊ธฐ์ ์ผ๋ก ์ด์ด ํ๊ธฐ๋ฅผ ์์ผ์ฃผ๋ ๊ฒ๋ ์ข์ต๋๋ค.
- ํํ๊ธฐ ์ฌ์ฉ: ์์ค์ด๋ ์ฃผ๋ฐฉ์์ ์ค์, ์๋ฆฌ ํ์๋ ๋ฐ๋์ ํํ๊ธฐ๋ฅผ ์ผ์ ์ต๊ธฐ๋ฅผ ์ ๊ฑฐํด์ผ ํฉ๋๋ค.
๊ณฐํก์ด ์๋ ์พ์ ํ ๊ณต๊ฐ, ์ด์ ๋น์ ์ ์์ผ๋ก!
๊ณฐํก์ด๋ ๊ฑด๊ฐ๊ณผ ์ํ ํ๊ฒฝ์ ์ํํ๋ ๋ถ์ฒญ๊ฐ์ ๋๋ค. ํ์ง๋ง ์ค๋ ์๋ ค๋๋ฆฐ ๋ฐฉ๋ฒ๋ค์ ํตํด ๊ณฐํก์ด๋ฅผ ์ ๊ฑฐํ๊ณ ์๋ฐฉํ๋ฉด ๊ณฐํก์ด ์๋ ์พ์ ํ ๊ณต๊ฐ์ ๋ง๋ค ์ ์์ต๋๋ค.
"๊นจ๋ํ ์ง์ ๊ฑด๊ฐํ ์ถ์ ์์์ ๋๋ค." ์ง๊ธ ๋ฐ๋ก ๊ณฐํก์ด ์ ๊ฑฐ๋ฅผ ์์ํ๊ณ , ๊พธ์คํ ๊ด๋ฆฌํ์ฌ ๊ณฐํก์ด ๊ฑฑ์ ์๋ ๊ฑด๊ฐํ ์ถ์ ๋๋ฆฌ์ธ์!